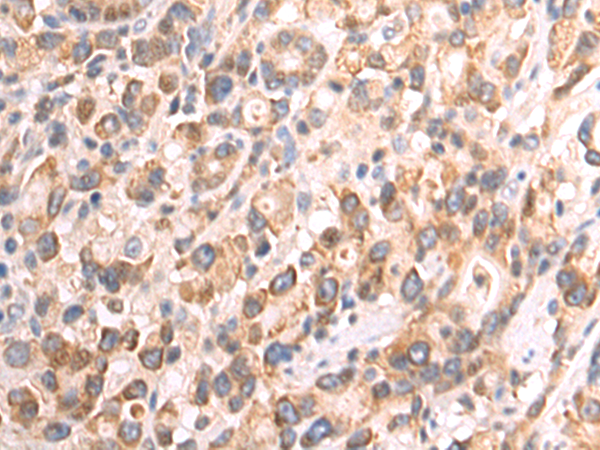

-
分类: 科研抗体货号: P07217别名: EB1; SCAF1; SCAFI; SIG81; COX7AR; COX7RP应用: WB,IHC反应种属: Human, Mouse
-
分类: 科研抗体货号: P07218别名: COX11P应用: WB,IHC反应种属: Human, Mouse
-
分类: 科研抗体货号: P07246别名: LIT; DCR1; TRID; CD263; TRAILR3; TRAIL-R3; DCR1-TNFR应用: IHC反应种属: Human
-
分类: 科研抗体货号: P07216别名: NOC4, COX4NB, C16orf2, C16orf4, FAM158B应用: WB,IHC反应种属: Human, Mouse, Rat
-
分类: 科研抗体货号: P07243别名: DCIR; LLIR; CD367; DDB27; CLECSF6; HDCGC13P应用: WB,IHC反应种属: Human
-
分类: 科研抗体货号: P07213别名: EDS4A应用: IHC反应种属: Human, Mouse, Rat
-
分类: 科研抗体货号: P07239别名: HLP; CP33; CP34; CYP3A; NF-25; CYP3A3; P450C3; CYPIIIA3; CYPIIIA4; P450PCN1应用: WB,IHC反应种属: Human
-
分类: 科研抗体货号: P07212别名: AOM; ANFH; SEDC; STL1; COL11A3应用: WB,IHC反应种属: Human, Mouse, Rat
-
分类: 科研抗体货号: P07237别名: AHH, AHRR, CP11, CYP1, P1-450, P450-C, P450DX应用: WB,IHC反应种属: Human, Mouse, Rat
-
分类: 科研抗体货号: P07211别名: 3MC2; CLK1; CL-K1-I; CL-K1-II; CL-K1-IIa; CL-K1-IIb应用: IHC反应种属: Human, Mouse

鄂公网安备42018502007531号
鄂公网安备42018502007531号

